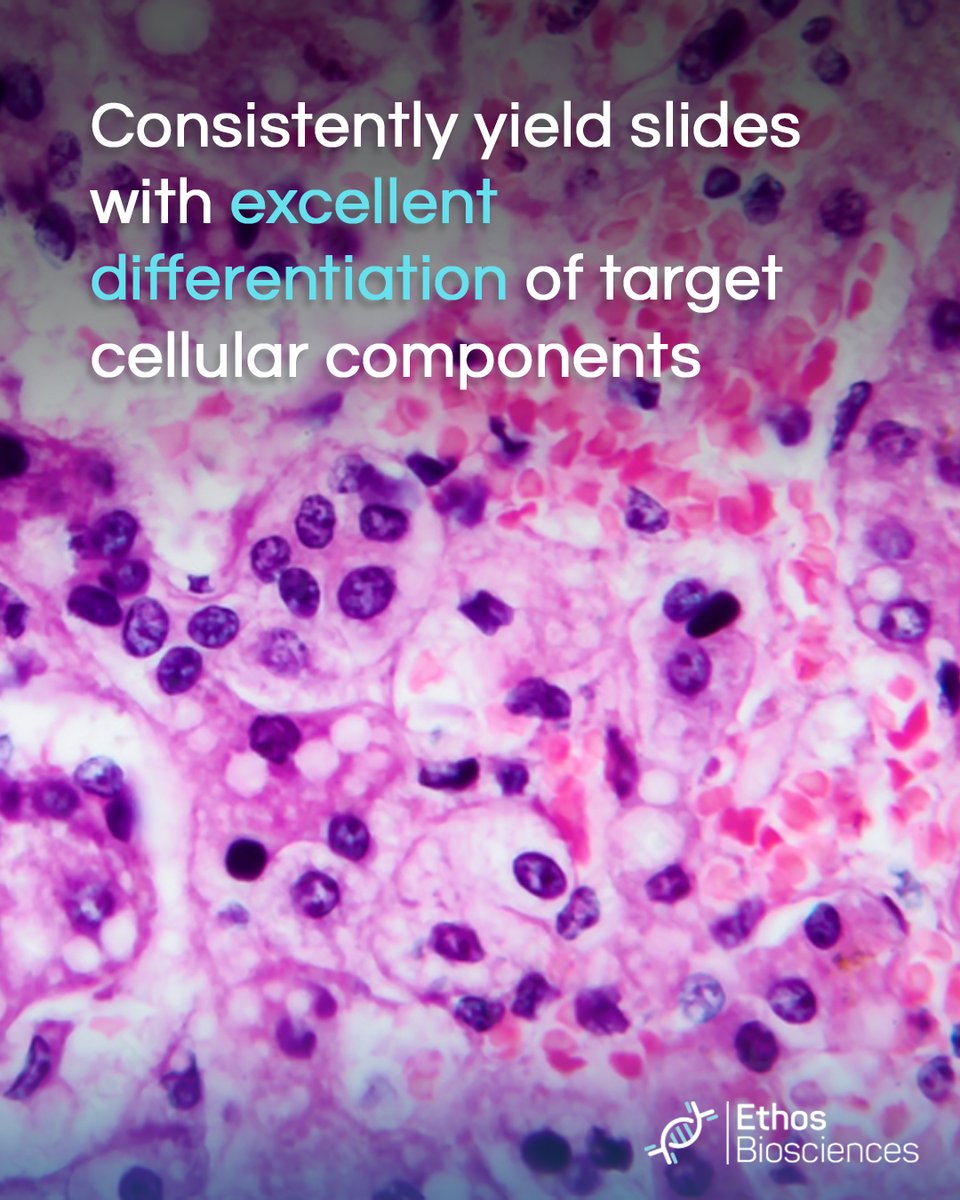
Ethos Biosciences - an Ott Scientific Company tweet media

ทวีตที่ปักหมุด

🔍 Looking for a reliable contract manufacturing partner? At Ethos Biosciences, we understand the challenges: ensuring expertise aligns with your product needs and securing robust technical support.
👍 Let’s address these concerns together!
📧 Connect with us at Service@EthosBiosciences.com or visit us at NSH Booth #340, September 26-30.
#ContractManufacturing #Biotech #NSH2025
English